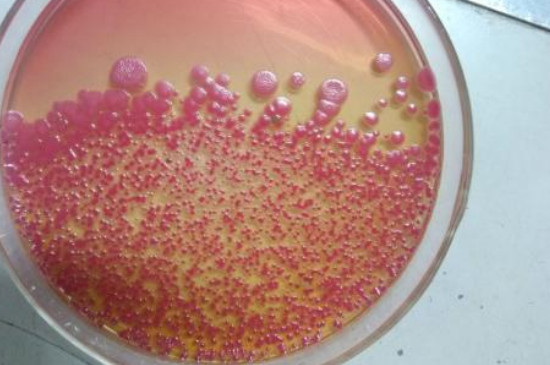

安祖花的繁殖方法有哪些?
安祖花的繁殖方法较多,可以扦插、分株、播种和组培。想要种养安祖花,需要根据不同的季节,进行合理的繁殖。扦插繁殖可在春季4~5月之间进行,分株繁殖可在春秋季期间进行。播种繁殖可在春季期间进行,组织培养四季都可进行。
1、扦插

安祖花属于草本植物,可以扦插繁殖,适合在春季4~5月之间进行。剪取母株1~2个茎节,确保茎节上有2~4枚叶片,粘上适量的生根粉。将其扦插在疏松、肥沃且透气的营养土里,养护期间需要控水,一般1~2个月可长出根系。
2、分株

安祖花也可以分株繁殖,一般适合在春季或秋季期间进行。选择健壮无病的母株,分出母株上健壮且有完整根系的侧芽。选择疏松、透气和排水性能良好的土壤,将安祖花的幼株种植在盆土中,养护期间要控水,还要避免阳光照射。
3、播种

安祖花可以播种繁殖,可在春季期间进行播种。选择安祖花饱满健壮的种子,将其播撒在疏松、透气且肥沃的土壤中。播种后需要适量的浇水将土壤浸湿,养护期间温度需控制在25~28度之间,保持土壤湿润,一般25天左右可出芽。
4、组培
安祖花还可以组织培养,安祖花的茎和嫩叶等部位可以进行组培。在组培前,需要给安祖花茎芽或是嫩叶等部位进行清洗和消毒。后期可以接种培养,叶片愈合后可分化形成芽,控制好环境的温度,可使安祖花萌发和生长。










